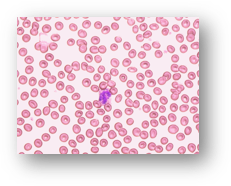

GENERAL BIOLOGY 1
LESSON : Introduction of General Biology 1
This subject is designed to enhance the understanding of the principles and concepts in the study of biology, particularly life processes at the cellular and molecular levels. It also covers the transformation of energy in organisms.
| IMPORTANT TERMS |
|---|
| • Universe - made up of galaxies, planets, asteroids and other celestial bodies**• Biology -** is the scientific study of life, it is important because it helps us understand how living things work and function**• Earth -** is the planet we humans live on and is the known place that supports and has life |
FIVE CATEGORIES OF LIFE
1. Kingdom Animalia - or metazoa is
characterized by multicellular, eukaryotic
animal forms (includes all animals and
humans under class mammalia.
2. Kingdom Plantae - plant kingdom that
includes multicellular photosynthetic
eukaryotes which contains all the plants
on earth
3. Kingdom Protista - The Kingdom Protista
consists of eukaryotic protists. Members of
this very diverse kingdom are typically
unicellular and less complex in structure
than other eukaryotes. (ex.amoeba
protozoa-animal protist, algae)
4. Kingdom Fungi - usually multicellular
eukaryotic organisms that are heterotrophs
(cannot make their own food) and have
important roles in nutrient cycling in
an ecosystem. (ex.fungi, mushroom,yeast)
5. Kingdom Monera - the kingdom that is
made up of prokaryotes (particularly
bacteria). As such it is composed of
single-celled organisms that lack a nucleus.
THREE MAIN BRANCHES OF BIOLOGY
| Branches | Definition |
|---|---|
| 1. Zoology | the study of animals |
| 2. Botany | the study of plants |
| 3. Microbiology | the study of microorganisms |
SUB-BRANCHES OF BIOLOGY
| Branches | Definition |
|---|---|
| 1. Morphology | study of shapes and arrangement of parts of organisms |
| 2. Anatomy | the study of the physical structure of a body |
| 3. Histology | the study of microscopic structures of tissues |
| 4. Cell Biology | the study of cells (composition, function etc.) |
| 5. Physiology | the study of functions and mechanism in a living system |
| 6. Genetics | the study of heredity and variation |
| 7. Embryology | the study of embryos and their development |
| 8. Taxonomy | the study of classification |
| 9. EnvironmentalBiology | the study of how living organisms interact with their environment |
| 10. Sociobiology | the study of social behavior |
| 11. Parasitology | the study of parasitic organisms |
| 12. Biotechnology | the study of the use of living organisms and systems for the development of products |
| 13. Immunology | the study of the immune system |
| 14. Entomology | the study of insects |
| 15. Pharmacology | the study of the effects of drugs and chemicals on living organisms |
| 16. MolecularBiology | the study of various biological activities at the molecular level |
LESSON 1 : Cell Theory
In biology, cell theory is the historic scientific theory, now universally accepted, that living organisms are made up of cells, that they are the basic structural/organizational unit of all organisms, and that all cells come from pre-existing cells. Cells are the basic unit of structure in all organisms and also the basic unit of reproduction.
HISTORY OF THE CELL THEORY
1665 ROBERT HOOKE
- English scientist that discovered cells while looking at a thin slice of cork
- Described the cells as honeycomb/tiny boxes
- Flaw : He thought cells only existed in plants and fungi
1763 ANTONIE VAN LEEUWENHOEK
- Used a handmade microscope to observe a pond scum and **discovered single-celled organisms called “**animalcules”
- He observed blood cells of animals and humans , so it was known that cells are also found in animals
MID 19TH CENTURY
SPONTANEOUS GENERATION
- It is the supposed production of living organisms from nonliving matter (ex. maggots from rotting meat)
- Little cell advancements were made due to widely accepted, traditional belief of spontaneous generation
- John Needham’s experiment tried to prove the theory but it had a flaw (the flask was not sealed and was exposed to air)
DEBUNKMENT OF SPONTANEOUS GENERATION
- Francesco Redi’s Experiment
- Refuting spontaneous generation of maggots in meat. The uncovered jars had maggots while the covered jars did not have any
- Lazzaro Spallanzani’s Experiment
- Sterilized broth in two flasks, one is sealed and the other is not
- Concluded that the sealed flask with broth did not produce life, and that organisms entered through the air
- Louis Pasteur’s Experiment
- In 1862, he conducted experiments that rejected the idea of spontaneous generation
1838 MATTHIAS SCHLEIDEN
- German botanist that concluded that all plant parts are made of cells
1839 THEODORE SCHWANN
- German physiologist stated that all
animal tissues are composed of cells
1858 RUDOLF VIRCHOW
- German physician after extensive study
concluded that cells must arise from
pre-existing cells
| THE 3 BASIC COMPONENTS OF THE CELL THEORY |
|---|
| All organisms are composed of one or more cells (Schleiden & Schwann 1838-1839) |
| The cell is basic unity of life in all living things (Schleiden & Schwann) |
| All cells are produced by the division of pre-existing cells (Virchos, 1858) |
How the Cell Theory has been used ?
- Serves as a basis for things such as Disease/Health/Medical Research and Cures
- Ex. AIDS, Cancer, Vaccines, Cloning, Stem Cell Research
LESSON 2 : The Cell Organelles
Cells are very similar to factories. To stay alive and function properly, cells have a division of labor similar to that found in factories. Here we will examine cells as protein-producing factories.
What is an Organelle ?
- also called “little organs”
- found only inside eukaryotic cells
- the stuff between the organelles
- is cytosol
- everything in the cell except the
- cells is cytoplasm
PARTS OF A CELL AND ITS FUNCTIONS
| PARTS | FUNCTION & STRUCTURE |
|---|---|
| 1. CellMembrane | - boundary of the cell- made of phospholipid bilayer(hydrophilic heads andhydrophobic tails) |
| 2. Nucleus | - control center of the cell- it contains DNA and issurrounded by a double membrane- usually the easiest to seeunder a microscope |
| 3. Cytoskeleton | - acts as skeleton and muscle- provides shape and structure- helps move organelles- made of 3 types of filamentsmicrotubules : 25-nm diameteractin : 7-nm diameterintermediate : 10-nm diameter |
| 4. Microtubules | - aids in cell division and isusually found only in animalcells |
| 5. EndoplasmicReticulum | - highway of the cell and is alsoknown as “ER”- connected to nuclearmembrane- *Rough ER* : has ribosomes andmakes proteinsSmooth ER : no ribosomes andmakes lipids |
| 6. Ribosomes | - site of protein synthesis and isattached to the rough er orfloatin free in cytosol- produced in the nucleolus |
| 7. Golgi Body | - also known as Golgi Complex- stores, modifies and packagesproteins |
| 8. Lysosome | - garbage disposal of the cell- contains digestive enzymesthat break down wastes |
| 9. Mitochondria | - powerhouse of the cell- site of cellular respiration- has its own DNA strand |
| 10. Chloroplast | - found only in plant cells- contains chlorophyll (greenpigment that is essential tophotosynthesis)- site of **food(glucose)**production |
| 11. Vacuole | - large central vacuole is usuallyin plant cells- smaller ones in animal cells- storage container for waterfood enzymes, wastes,pigments, etc. |
| 12. Cell Wall | - rigid, protective barrier- located outside the cellmembrane- found in plant and bacterialcells and is made of cellulose |
LESSON 3 : Prokaryotic and Eukaryotic Cells
There are many different cells that do many different things, but all of these cells fall into one of two main categories : Prokaryotic Cells and Eukaryotic Cells
| PROKARYOTES | EUKARYOTES |
|---|---|
| Pro = beforeKaryose = kernel, which represents the nucleusDoes not have distinct nucleusEx. Bacteria | Eu = trueKaryose = kernel, the nucleusHave distinct/true nucleusEx. Animal, Plant & Fungi (yeast) |
DIFFERENCES : AGE & STRUCTURE
Scientists believe that prokaryotic cells (bacteria form) were the first life form on earth. Considered “primitive” and were discovered before eukaryotic cells.
- 4.6B years ago - Earth was formed
- 3.5B years ago - first life(prokaryotic bacteria)
- 1.5B years ago - eukaryotic cells
- 500M years ago - multi-celled eukaryotes
- 3M years ago - ancestors/hominids
| PROKARYOTIC CELLS | EUKARYOTIC CELLS |
|---|---|
| Older | New |
| No distinct nucleus | Has distinct nucleus |
| DNA floats around in the nucleoid (not a real structure) | DNA is in the membrane bound nucleus |
| Does not have membrane-bound organelles like eukaryotes | Have membrane-bound organelles |
| Organelles perform simple functions | Organelles can perform more complex functions |
| Smaller | 10x bigger than prokaryotes |
SIMILARITIES
- Both has DNA (Deoxyribonucleic Acid), cell/plasma membrane and cytoplasm
- Ribosomes : simple in prokaryotic
complex in eukaryotic
- Allow the flow of nutrients and wastes to enter and leave the cell
- Have similar metabolic processes like photosynthesis and respiration
- Made from the same basic chemicals namely carbohydrates, protein, nucleic acid, fats, minerals and vitamins
- Require a supply of energy
TWO THEORIES TO EXPLAIN THE ORIGIN
OF MEMBRANE-BOUND ORGANELLES
- Endosymbiosis - (origin of chloroplasts and mitochondria) suggests that chloroplasts and mitochondria were once bacteria that developed a symbiotic relationship with cells that have nucleus.
- chloroplasts and mitochondria have their own DNA that is not part of the cells
- Invagination - (nucleus and other organelles) folding of plasma membrane to form the endomembrane system .
| DEFINITION OF TERMS |
|---|
| Plasmids - genetic structure in a cell that can replicate chromosomes independently Nucleoid - not a real structure but a word to describe where the nuclear material sits (prokaryotic cells)Flagella & Cilia - structure that helps cells move |
| Recently, discoveries suggests that prokaryotic cells also exists in multi-celled groups such as organs and tissues like eukaryotes |
|---|
LESSON 4 : Plant Tissue
LEVELS OF ORGANIZATION
- Atomic-level- Atoms are defined as the smallest unit of an element that still maintains the property of that element.
examples:
Carbon, Hydrogen, Oxygen
- Molecular level- Atoms combine to form molecules.
- Cell- smallest unit of life.
- Tissue- a group of cells with similar functions.
- Organ- groups of tissues that work together to complete a specific task
- Organ system- A group of organs that carries out a more generalized set of functions
- Organism- has several organ systems that function together.
PLANT TISSUE SYSTEMS
- Meristematic tissue system
Also called meristems, are tissues in which the cells remain forever young and divide actively throughout the life of the plant. They possess a large nucleus devoid of the vacuole. The cells have no intercellular space.
PERMANENT TISSUE SYSTEMS
1. Dermal Tissue system
Provides protection and prevention from water loss
- Epidermis
- Trichomes- protect plants from UV light, insect predation, and excess transpiration
- Root hairs- They absorb nutrients and water which are sent through the tip of the plant's root.
- Cuticle- the outermost layer of plants. It protects plants against drought, extreme temperatures, UV radiation, chemical attack, mechanical injuries, and pathogen/pest infection.
- Stomata- pores in plant tissue that allows gas exchange.
- Periderm \n A group of tissues that replaces the epidermis in the plant body. Its main function is to protect stems and roots.
2. Ground Tissue system
Photosynthesis, food storage, regeneration, support, and protection
- Parenchyma tissue
For photosynthesis, storage, secretion, assimilation, respiration, excretion, and radial transport of water and solute. They are living permanent tissues that have the ability to divide at maturity and help in the regeneration and healing of wounds.
- Collenchyma tissue
Has the ability to store water and can swell up to 200% when they absorb water.
- Sclerenchyma tissue
It is a supportive tissue and is usually made up of dead cells with highly thickened lignified walls.
- Sclereids- it has very narrow cavities and is hard and inflexible. They form protective coverings such as seed coats, shells of nuts, etc.
- Fibers- They are elongated, needle-like pointed sclerenchyma cells. They are often dead at maturity and lack a nucleus and cytoplasm.
3. Vascular tissue system
Transport of water, minerals, and food.
- Xylem tissue
is a tissue that carries water and minerals from the soil to the leaves and stems.
- Tracheids- the first tracheary component discovered in the xylem. Some gymnosperms and other seedless plants only have tracheids as their main component for conducting water.
- Vessel elements- the second tracheary component in the xylem. Compared to the tracheids, they are highly specialized cells. The main component, also known as the vessel element, transports water in angiosperms even when tracheids are present. It is absent in gymnosperms,
- Phloem tissue
The vascular plant tissue, phloem, is responsible for distributing and transporting carbohydrates produced during photosynthesis. The phloem is composed of living tissue that actively transports sugars to plant organs using turgor pressure and energy in the form of ATP(adenosine triphosphate.
Note: Translocation is the term for this movement process.
- Sieve elements- made up of rows of sieve tube cells with holes in their lateral walls, facilitating the movement of nutrients throughout the plant.
- Companion cells- work alongside the sieve tube cells to support the metabolic processes of the sieve components.
LESSON 5 : Animal Tissue
The cells of humans and other animals have a cell membrane, but they do not have a stiff cell wall . They cannot make their own food and do not have chloroplasts. However there is a great variety to their shapes.
FOUR TYPES OF ANIMAL TISSUE
- EPITHELIAL TISSUE (Covering)
- Lines body surfaces and cavities, as well as form glands
- Closely connected to each other via cellular junctions
- Found on the edges of organs
- Can be classified based on the number of cell layer and shape of the cell
1. Squamous - (flattened, like floor tiles
2. Cuboidal - (cubic shape like dice)
3. Columnar (column shape like brick
- Does not contain blood vessel and are dependent upon underlying connective tissue
- Simple : single layer of cells
Stratified : multiple tiers of cells
- Apical Surface - exposed to the body cavity/exterior
Basal Surface - adjacent to the underlying tissue
| TYPES | FUNCTION |
|---|---|
| Simple Squamous Epithelium | - comprises the inner lining ofblood vessels, where it provide a smoothsurface that reduces friction as bloodtravels through the vessels- Example : walls of alveoli (lung air sacs) |
| Simple CuboidalEpithelium | - active in absorption and secretion ofof various substances- consists of a single layer of cuboidalcells- Example : tubules of the kidney |
| Simple Columnar Epithelium | - absorption of nutrients- Example : intestinal lining |
| Stratified Squamous Epithelium | - consists of multiple layers of squamouscells at the apical surface- this type is mainly for protectingunderlying tissues- found where abrasions may occur- Example: skin, mouth, esophagus |
| Pseudostratified Columnar Epithelium | - formed by a single layer of cells thatgive the appearance of being made frommultiple layers- secretion of mucus and protection ofrespiratory tract- Example : Nasal Passage |
- CONNECTIVE TISSUE (Support)
- Characterized by the presence of extracellular matrix (non-living material composed of protein fibers and ground substance)
- The protein fibers are made of collagen(for strength) or elastin (for flexibility)
- Functions : structural support, connections, protection
- Blood is considered a connective tissue
Cells of Connective Tissue
- The name of the cell identifies the cell function by means of these suffixes : -blast, -cyte, or -clast
- Blast (create matrix) , Cyte (maintain it) Clast (break it down)
Connective Tissue Proper
- **Loose Connective Tissue -**consists of relatively few protein fibers that form a lacy/loose framework, soft and pliable that serves as a packing material between tissues and organs,
found between muscles and supports blood and/lymphatic vessels and nerves
3 TYPES OF LOOSE CT
- Adipose : composed of adipocytes and
stores energy in the form of fat,
insulates the body
- Areolar : supports internal organs
- Reticular : form a stroma and provide
structural support
- Dense Connective Tissue - has a greater proportion of fibers that are densely packed, fewer cells and less ground substance
Location : tendon(muscle to bone) and ligaments(bone to bone)
3 CATEGORIES OF DENSE CT
- Dense Regular
- Dense Irregular
- Elastic
Supporting Connective Tissue
- Bone - mineralized connective tissue (hydroxyapatite) osteoblasts bone forming cells deposited in a matrix of collagen , once they are trapped for secretion , they are called osteocytes (mature bone cell)
Compact bone consists of repeating unit called osteon or haversian system
- Cartilage - supports structure such as the nose, ears, and joint surfaces, its cells are called chondrocytes
types of cartilage
a. hyaline - most widely distributed
b. elastic - has collagen-containing matrix, flexible when deformed
c. fibrocartilage - hybrid tissue found in intervertebral disks and associated with dense fibrous tissue tendons and ligaments
Fluid Connective Tissues
- Blood - matrix plasma consisting water, salts and dissolved proteins
types of blood cells
a. red blood cells - erythrocytes, transports oxygen, carbon dioxide, hormones, nutrients and other substances
b. white blood cells - leukocytes, antibodies/protects the body from infection and is involved in temperature regulation
ex. neutrophile, basophile, eosinophile, monocytes, agranulocytes, and lymphocytes
c. platelets - small, colorless fragments that forms clots to prevent bleeding
3. MUSCLE TISSUE (Movement)
- it contracts or shortens(specialized cell) with a force and therefore is responsible for movement of internal organs and locomotion of the entire organism
- its cells are contractile cells
THREE TYPES OF MUSCLE TISSUE
- Skeletal Muscle
- has striated tubular, multinucleated fiber
- usually attached to skeleton
- is voluntary
- Cardiac Muscle
- has striated, branched, uninucleated fibers
- is involuntary
- Smooth Muscle
- has spindle-shaped, non striated uninucleated fibers
- occurs in walls of internal organs.
- is involuntary
TYPES OF PROTEINS
- Myosin - motor protein for muscle contraction
- Actin - spherical protein that forms filaments, involved in muscle contraction and other cellular processes
- Tropomyosin - long strand that loops around actin chains
4. NERVOUS TISSUE (Control)
- composed of two major types of cells : neurons and support cells/glia
- found in the brain, spinal cord, and nerves
- characterized by the ability to conduct electrical signals called action potential neurons
- are responsible for its conductive ability
- Neurons - specialized for sending signals/electrical impulse rapidly over long distances to other cells
composed of three major parts
a. axon - takes information away from the cell body
b. dendrite - brings information to the cell body
c. cell body - site of general cell functions
SUMMARY :
LESSON 6 : Cell Modification
CELL MODIFICATION
- or specialization/differentiation is a process that occurs after cell division where the newly formed cells are structurally modified so that they can perform their function efficiently and effectively
- Small Intestine : highly folded surface to increase absorption of nutrients
- Villi - finger-like projection on SI wall
- Microvilli : projection on each cell
- Root Hairs : extension of root epidermal cells increase surface area for absorbing water and minerals
LESSON 7 : Cell Cycle
Interphase
- G1= Primary growth phase
- S = Synthesis; DNA replicated
- G2= Secondary growth phase
Cell division
- Karyokinesis(Division of Nucleus)
- Mitosis(Somatic/body cells except for brain & nerve cells)
- Meiosis(Gametes/Germ/sex cells)
- Cytokinesis(division of cytoplasm)
| G1 | 1st growth stageCells mature by making more cytoplasm and organellesCarries on its normal metabolic activities |
|---|---|
| S | Synthesis stageDNA is copied or replicated |
| G2 | 2nd growth stageAll cell structures needed for division are madeBoth Organelles and proteins are synthesized |
LESSON 8 : Mitosis
What is Mitosis?
- Mitosis is the division of the nucleus
- a process of cell duplication, or reproduction, during which one cell gives rise to two genetically identical daughter cells.
- also called “karyokinesis”
- Only occurs in eukaryotes
- Has 4 stages namely ; prophase, metaphase, anaphase and telophase
- Does not occur in some cells such as brain cells
FOUR MITOTIC STAGES
- Prophase : DNA forms into chromosomes, nuclear membrane and nucleolus disappear
| Early Prophase | Chromatin in nucleus condenses to form visible chromosomesMitotic fibers forms from fibers in cytoskeleton /centrioles**(animal)** |
|---|---|
| Late Prophase | nuclear membrane and nucleolus breaks downspindle fibers called kinetochores attach to the centromere of each chromosome |
Spindle Fibers - forms from the microtubules in plants and centrioles in animals
Polar Fibers - extend from one pole to the other
Kinetochore Fibers - extend from the pole to the centromere of the chromosome
Asters - short fibers radiating from centrioles
- Metaphase : Chromosomes line up in the middle of cell
- Kinetochores attach chromosome to mitotic spindle and align them along metaphase plate at equator
- moves to the center
- Anaphase : Chromatid arms separate and move to opposite ends of the cell.
- Occurs rapidly
- Sister chromatids are pulled apart to the opposite poles of the cell by kinetochore fibers
- Telophase : Chromosomes reach poles of cell
- Sister chromatids at opposite poles
- Spindle disassembles
- Nuclear envelope forms around each sister chromatid
- Nucleolus reappears
- Cytokinesis (division of cytoplasm) occurs
- Chromosomes reappear as chromatin
Daughter Cells of Mitosis
- Have the same number of chromosomes as the parent cell
- Identical to each other, but smaller than parent cell
- Must grow in size to become mature cells (G1 of interphase)
GENERALIZATION
- Multicellular organism grows by repeated cell division
- Each cell contains 23 pairs of chromosomes or 46
LESSON 9 : Meiosis
QUIZ 1
QUIZ 2
QUIZ 3
QUIZ 4
QUIZ 5
QUIZ 7
QUIZ 8